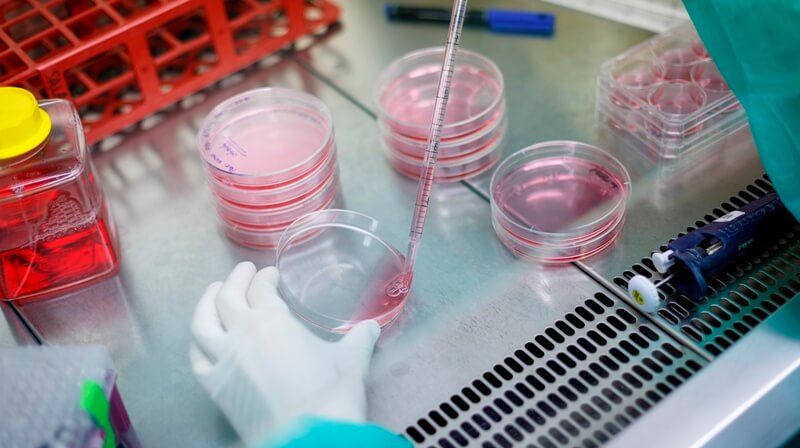

Nace el Comité de Bioseguridad de la Universitat de Barcelona
El martes 1 de marzo se constituyó el Comité de Bioseguridad de la Universidad de Barcelona (UB), creado por acuerdo del Consejo de Gobierno con fecha 16 de julio de 2015, con la finalidad de asesorar, evaluar y apoyar a la Universidad en las tareas de investigación científica y las actividades de docencia que impliquen la utilización de agentes biológicos, y de velar porque se cumplan las obligaciones exigidas por la normativa en materia de bioseguridad.
El nuevo Comité de Bioseguridad está presidido por Jordi Alberch, vicerrector de Investigación, Innovación y Transferencia, y los otros miembros son: Pedro Moreno, jefe de la Oficina de Seguridad, Salud y Medio Ambiente (OSSMA), que es el secretario del Comité; los profesores Sílvia Atrian, del Departamento de Genética y del Instituto de Biomedicina de la UB (IBUB); Raquel Martín, del Departamento de Biología Celular, Inmunología y Neurociencias; David Miñana, del Departamento de Microbiología y Parasitología Sanitarias, y Anna Planavila, del Departamento de Bioquímica y Biología Molecular (Biología), así como los técnicos del OSSMA Begoña Castillejos y José Ramón Gumiel y un representante del Comité de Seguridad y Salud.
El nuevo órgano está compuesto por un grupo especializado y multidisciplinario que trabajará de manera voluntaria e independiente, con la exigencia de confidencialidad en relación con las actividades que pueda evaluar, y en coordinación con la Oficina de Seguridad, Salud y Medio ambiente (OSSMA), el Comité de Ética y Experimentación Animal (CEEA) y otros comités de la UB en todos los aspectos de los proyectos de investigación o actividades de docencia (actividad e infraestructura) relacionados con la seguridad, la salud y el medio ambiente, cuando se utilicen agentes biológicos.
La utilización en la investigación o la docencia de agentes biológicos —que incluye organismos modificados genéticamente (OMG) y muestras potencialmente contaminadas con agentes biológicos– puede implicar daños para la salud humana y el medio ambiente. Hay una amplia legislación que exige que se cumplan medidas de seguridad y salud aplicables a las instalaciones y al personal que lleva a cabo su actividad.
Por otro lado, los modelos de solicitud de proyectos de investigación de diferentes convocatorias así como la adquisición de determinados OMG para la investigación exigen la autorización del órgano de la institución que tiene competencias en bioseguridad que acredite que se dispone de las instalaciones con condiciones de bioseguridad adecuadas para la experimentación propuesta.
En este contexto, el acuerdo de constitución establece como objetivos generales del Comité de Bioseguridad: mejorar la calidad de la investigación y de las prácticas docentes de la UB; favorecer que en la investigación y en las prácticas docentes de la UB que se hagan con agentes biológicos se promuevan los valores de la información, la precaución y la prevención de riesgos personales, laborales y de protección medioambiental; velar por el cumplimiento de la normativa vigente en materia de bioseguridad; promover la información y formación en materia de seguridad en la investigación y las prácticas docentes con agentes biológicos, y elaborar los informes que los miembros de la comunidad universitaria le soliciten.




